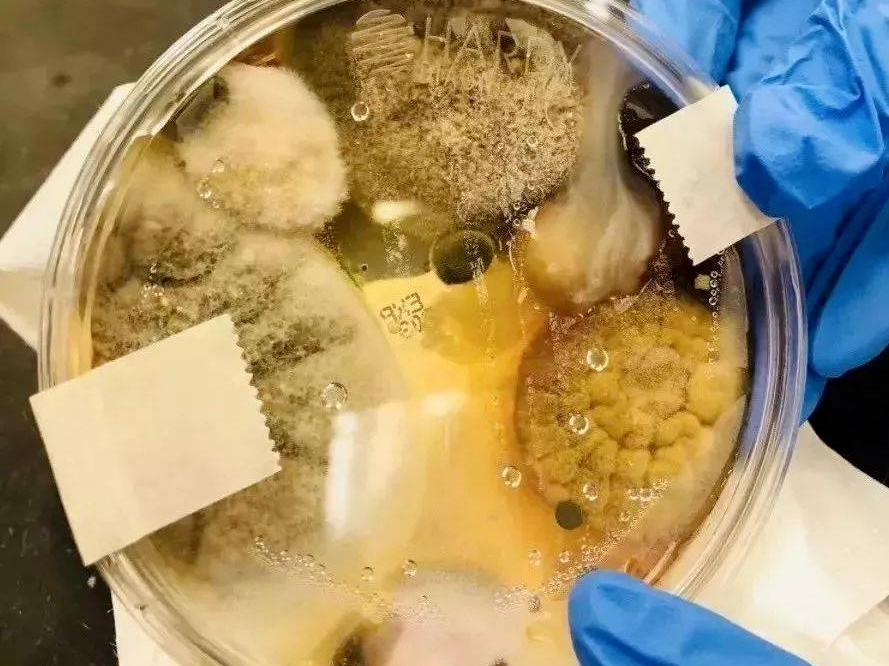

į┌╔╠ł÷Īó▄暊Īó▓═Åd└’Ą─
╣½╣▓Ä·╦∙└’
┤¾╝ę╩Ū▓╗╩ŪĮø│Ż┐┤ĄĮ
▀@ā╔śė¢|╬„
Ī²Ī²Ī²

Ž╚ė├Ž┤╩ųę║░č╩ų┤ĻĖ╔ā¶
į┘ė├║µ╩ųÖC┤ĄĖ╔
▀@┐┤ų°║├Ž±Ė╔ā¶ėųĘĮ▒Ń
Ą½▒žĒÜ╠ßąč┤¾╝ę
╣½╣▓Ä·╦∙Ą─▀@ā╔śė¢|╬„Ż¼ę¬ąĪą─ŻĪ
Į³╚šŻ¼╔Ņ█┌ąlĮĪ╬»
Š═░l▓╝┴╦▀@├┤ę╗ät╠ßąč

╣½Ä·└’Ą─Ž┤╩ųę║
▒Ē├µ┐┤ų°╚╦ą¾¤o║”
Ą½▒│║¾╩Ū─ŃŽļŽ¾▓╗ĄĮĄ─┼K
╣½╣▓ģ^ė“Ž┤╩ųę║╝ÜŠ·│¼ś╦╔ŽŪ¦▒Č
čļęĢžöĮøĪČ╩ŪšµĄ─åßĪĘÖ┌─┐
ū÷▀^ę╗┤╬Ī░╣½╣▓ł÷╦∙Ž┤╩ųę║š{▓ķĪ▒
ĮY╣¹░l¼FŻ║
║▄ČÓ╔╠ł÷Īó▓═Åd└’
Ž┤╩ųę║╝ÜŠ·│¼ś╦

▀@╩Ū╩▓├┤Ė┼─ŅŻ┐
Ž┤╩ųę║ęčĮø▓╗╩ŪŽ┤╩ųę║
Š═╩ŪĪ░╝ÜŠ·┼ÓB╗∙Ī▒ŻĪŻĪ
Č°Ž±▀@śėĄ─š{▓ķ─Ļ─ĻČ╝ėą
─Ļ─ĻĮY╣¹Č╝ę╗śė

▀@śė┐┤üĒ
Ž┤═Ļ┴╦Ę┤Č°▓╗╚ń▓╗Ž┤

å¢Ņ}üĒ┴╦
╣½╣▓Ä·╦∙└’Ą─Ž┤╩ųę║
×ķ╔ČŲš▒ķ▀@├┤┼KŻ┐
┤░Ė║▄║åå╬Ż║×ķ┴╦╩ĪÕX
į┌▒╗š{▓ķĄ─▓═ÅdĪóŠŲĄĻųą░l¼F
Ä·╦∙└’Ą─Ž┤╩ųę║
Ųš▒ķ┤µį┌ā╔éĆŪķør

┴ė┘|Ž┤╩ųę║▒Š╔ĒŠ═╝ÜŠ·│¼ś╦
į┘ę╗┤╬┤╬ōĮ╦«Ą─įÆ
╬ó╔·╬’Ģ■Ę▒ų│Ė³┐ņįņ│╔Č■┤╬╬█╚Š
▀@ĘNŠ═╩ŪōĮ╦«▒╚▌^ć└ųžĄ─Ż║
╔Ž├µ╬ęéāųvĄĮ┴╦Ž┤╩ųę║Ą─Üóé¹┴”
║µ╩ųÖCŠ═Ė³×ķ┐õÅł┴╦
╣½╣▓Ä·╦∙Ą─║µ╩ųÖC
ĄĮĄūėąČÓ┼K
╣½╣▓Ä·╦∙Ą─║µ╩ųÖCę╗░ŃĘų×ķā╔ĘNŻ║

¤ošō──ĘN
╦³Ą─╣żū„įŁ└ĒČ╝╩Ūę╗śėĄ─Ż║
ę╗▀ģ▀M’LŻ¼ę╗▀ģ│÷’L
å¢Ņ}Š═į┌▀@Ż¼║µ╩ųÖCĄž╠ÄÄ·╦∙
▀M’L▀MĄ─┐╔╩ŪÄ·╦∙Ą─┐šÜŌ░ĪŻĪ

蹊┐╚╦åTė├ūŽ═ŌŠĆāxŲ„šš╔õ║µ╩ųÖC│÷¼F┴╦▀@Ę∙«ŗ├µŻ¼│÷’L┐┌Ą──ŪŲ¼³S╔½¢|¢|╚½Č╝╩Ū╝ÜŠ·╔§ų┴▀Ćėą║▄ČÓČ╝ćŖĄĮ┴╦ē”╔Ž
ć°═Ō蹊┐╚╦åTū÷┴╦ę╗éĆįć“ׯ║
░čę╗éĆĖ╔ā¶Ą─Ąū▒P
Ę┼▀M╣½╣▓Ž┤╩ųķgĄ─║µ╩ųÖC└’
āHāHĘ┼▀M╚ź┴╦╚²ĘųńŖ
Č╠Č╠Äū╠ņ║¾
Ż©ėął¾Ą└ĘQ╩Ū48ąĪĢrŻ®
┼ÓB├¾└’ķL│÷üĒ▀@ą®¢|╬„Ż║

šf░ū┴╦Ż¼║µ╩ųÖCŠ═╩Ū
░čÄ·╦∙╦∙ėąĄ─╝ÜŠ·╩š╝»ŲüĒ
╝»ųąćŖĄĮ─Ń╩ų╔ŽŻ¼╔§ų┴╚½╔Ē
▀@──└’▀Ć╩Ū║µ╩ųÖC
║åų▒Š═╩Ū╝ÜŠ·Ą─Ī░▐Zš©ÖCĪ▒
ßt╔·╠ßąčŻ║
▀@ā╔ŅÉ╚╦ūŅ║├äeė├╣½╣▓Ž┤╩ųę║
ī”ė┌▀@ŅÉą═Ą─Ž┤╩ųę║
╬ęéā┬Ā┬ĀīŻ╝ęį§├┤šfŻĪ
Ī²Ī²Ī²
ĪĪĪĪųąć°╝▓▓ĪŅAĘ└┐žųŲųąą─ŁhŠ│╦∙Ė▒ų„╚╬╝╝Ĥ└Ņز╠ßąčŻ║
ĪĪĪĪė├▀@śėĄ─Ž┤╩ųę║Ž┤╩ųŻ¼ĘŪĄ½▓╗─▄▀_ĄĮØŹā¶ļp╩ųĄ──┐Ą─Ż¼Ę┤Č°Ģ■ūī▓┐Ęų╝ÜŠ·Üł┴¶į┌╩ų╔ŽĪŻ╠žäe╩Ū«ö╩ų╔ŽėąØóŲŲŻ¼╗“š▀¾w┘|▒╚▌^╠ž╩ŌĄ─╚╦Ż¼╚ń╣¹╩╣ė├╝ÜŠ·║¼┴┐│¼ś╦Ą─Ž┤╩ųę║Ż¼╝ÜŠ·Ģ■═©▀^é¹┐┌▀M╚ļ¾wā╚ĪŻ
ĪĪĪĪ▌pĄ─įÆĢ■ī”╩ų╔ŽĄ─äō├µ«a╔·╗»─ōĖą╚ŠŻ╗╚ń╣¹Š·Ė³ČÓŻ¼╩ų╔Žäō├µĖ³┤¾Ż¼╦³Ģ■ų▒Įė▀M╚ļč¬ę║Ż¼ė╚Ųõ╩ŪŠG─ōŠ·║═ĮŲŽŠ·ę¬╩Ū▀M╚ļč¬ę║Ą─įÆŻ¼Ģ■«a╔·öĪč¬░YĪóŠ·č¬░YĪóŠ·ČŠč¬░YĄ╚Ż¼ģ¢║”Ą─įÆ▀Ć─▄ę²ŲŲõ╦¹╝▓▓ĪŻ¼╔§ų┴╬Ż╝░╔·├³ĪŻ
ĪĪĪĪĮŁ╠K╩Ī╚╦├±ßtį║č¬ę║┐ŲĖ▒ų„╚╬ßtÄ¤ÅłĢįŲGę▓▒Ē╩ŠŻ║
ĪĪĪĪ╚ń╣¹Ž┤╩ųę║┐é╩ŪāČ╦«Ż¼Č°ūįüĒ╦«▓╗╩Ū¤oŠ·╦«Ż¼Ž┤╩ųę║└’╝ÜŠ·Ģ■įĮüĒįĮČÓĪŻ╝┤╩╣╩ŪĮĪ┐ĄĄ─Ųš═©╚╦Ż¼į┌╩ųĮėė|╩│╬’Īó┐┌▒Ū║¾Ż¼▀@ą®╝ÜŠ·ę▓┐╔─▄═©▀^š│─żĪóŽ¹╗»Ą└įņ│╔Ėą╚Š▓óų┬▓ĪĪŻ
ĪĪĪĪ╦∙ęį▀@ā╔ŅÉ╚╦ūŅ║├äeė├╣½╣▓Ž┤╩ųę║Ż║
ĪĪĪĪ1. ╩ų╔ŽŲż─wėąé¹┐┌Ą─╚╦ĪŻ
ĪĪĪĪ2. ā║═»Īó└Ž╚╦╗“Ųõ╦¹├Ōę▀┴”Ą═Ž┬Ą─╚╦╚║ĪŻ
╝┤▒Ń╚ń┤╦
╬ęéā▀Ć╩Ūę¬▒Ż│ųŽ┤╩ųĄ─║├┴ĢæT
į┌═Ō├µŽ┤╩ųę▓ę¬ūóęŌĘĮ╩ĮåčŻĪ
╚ń║╬š²┤_Ž┤╩ųŻ┐
Ž┤╩ų▀@╝■Ī░ąĪ╩┬Ī▒Ż¼─ŃĢ■å߯┐
į┌═Ō├µŽ┤╩ų
ūŅ║├▀Ć╩Ūį┌ūįüĒ╦«²łŅ^Ž┬
ė├┴„äė╦«ø_Ž┤
ėąūįéõĄ─Ž┤╩ųę║╗“š▀Ę╩įĒ
ė├┴„äė╦«ø_Ž┤ų┴╔┘15├ļęį╔Ž
╚ń╣¹ø]ėąūįéõŽ┤╩ųę║
─ŪŠ═ė├ŪÕ╦«ø_Ž┤40~60├ļ
╚¶Ģrķg▀^Č╠Ż¼▓ĪŠ·╚▌ęūÜł┴¶į┌╩ų
│╔×ķ╔ó▓ź▓ĪČŠĄ─£ž┤▓
ø_═Ļ║¾ė├ūįéõĖ╔ā¶╝łĮĒ▓┴Ė╔Š═ok└▓~

╔·╗Ņ└’Ė„ŅÉ╝ÜŠ·¤o┐ū▓╗╚ļ
┤¾╝ęę╗Č©ę¬ūóęŌĮĪ┐Ą░▓╚½
▒Ż│ų┴╝║├Ą─╔·╗Ņ┴ĢæT║═ąl╔·┴ĢæT
╚ń╣¹╔Ē¾w│÷¼F▓╗▀m
▓╗ę¬═ŽčėĢrķg
šł╝░ĢrŠ═ßtų╬»¤